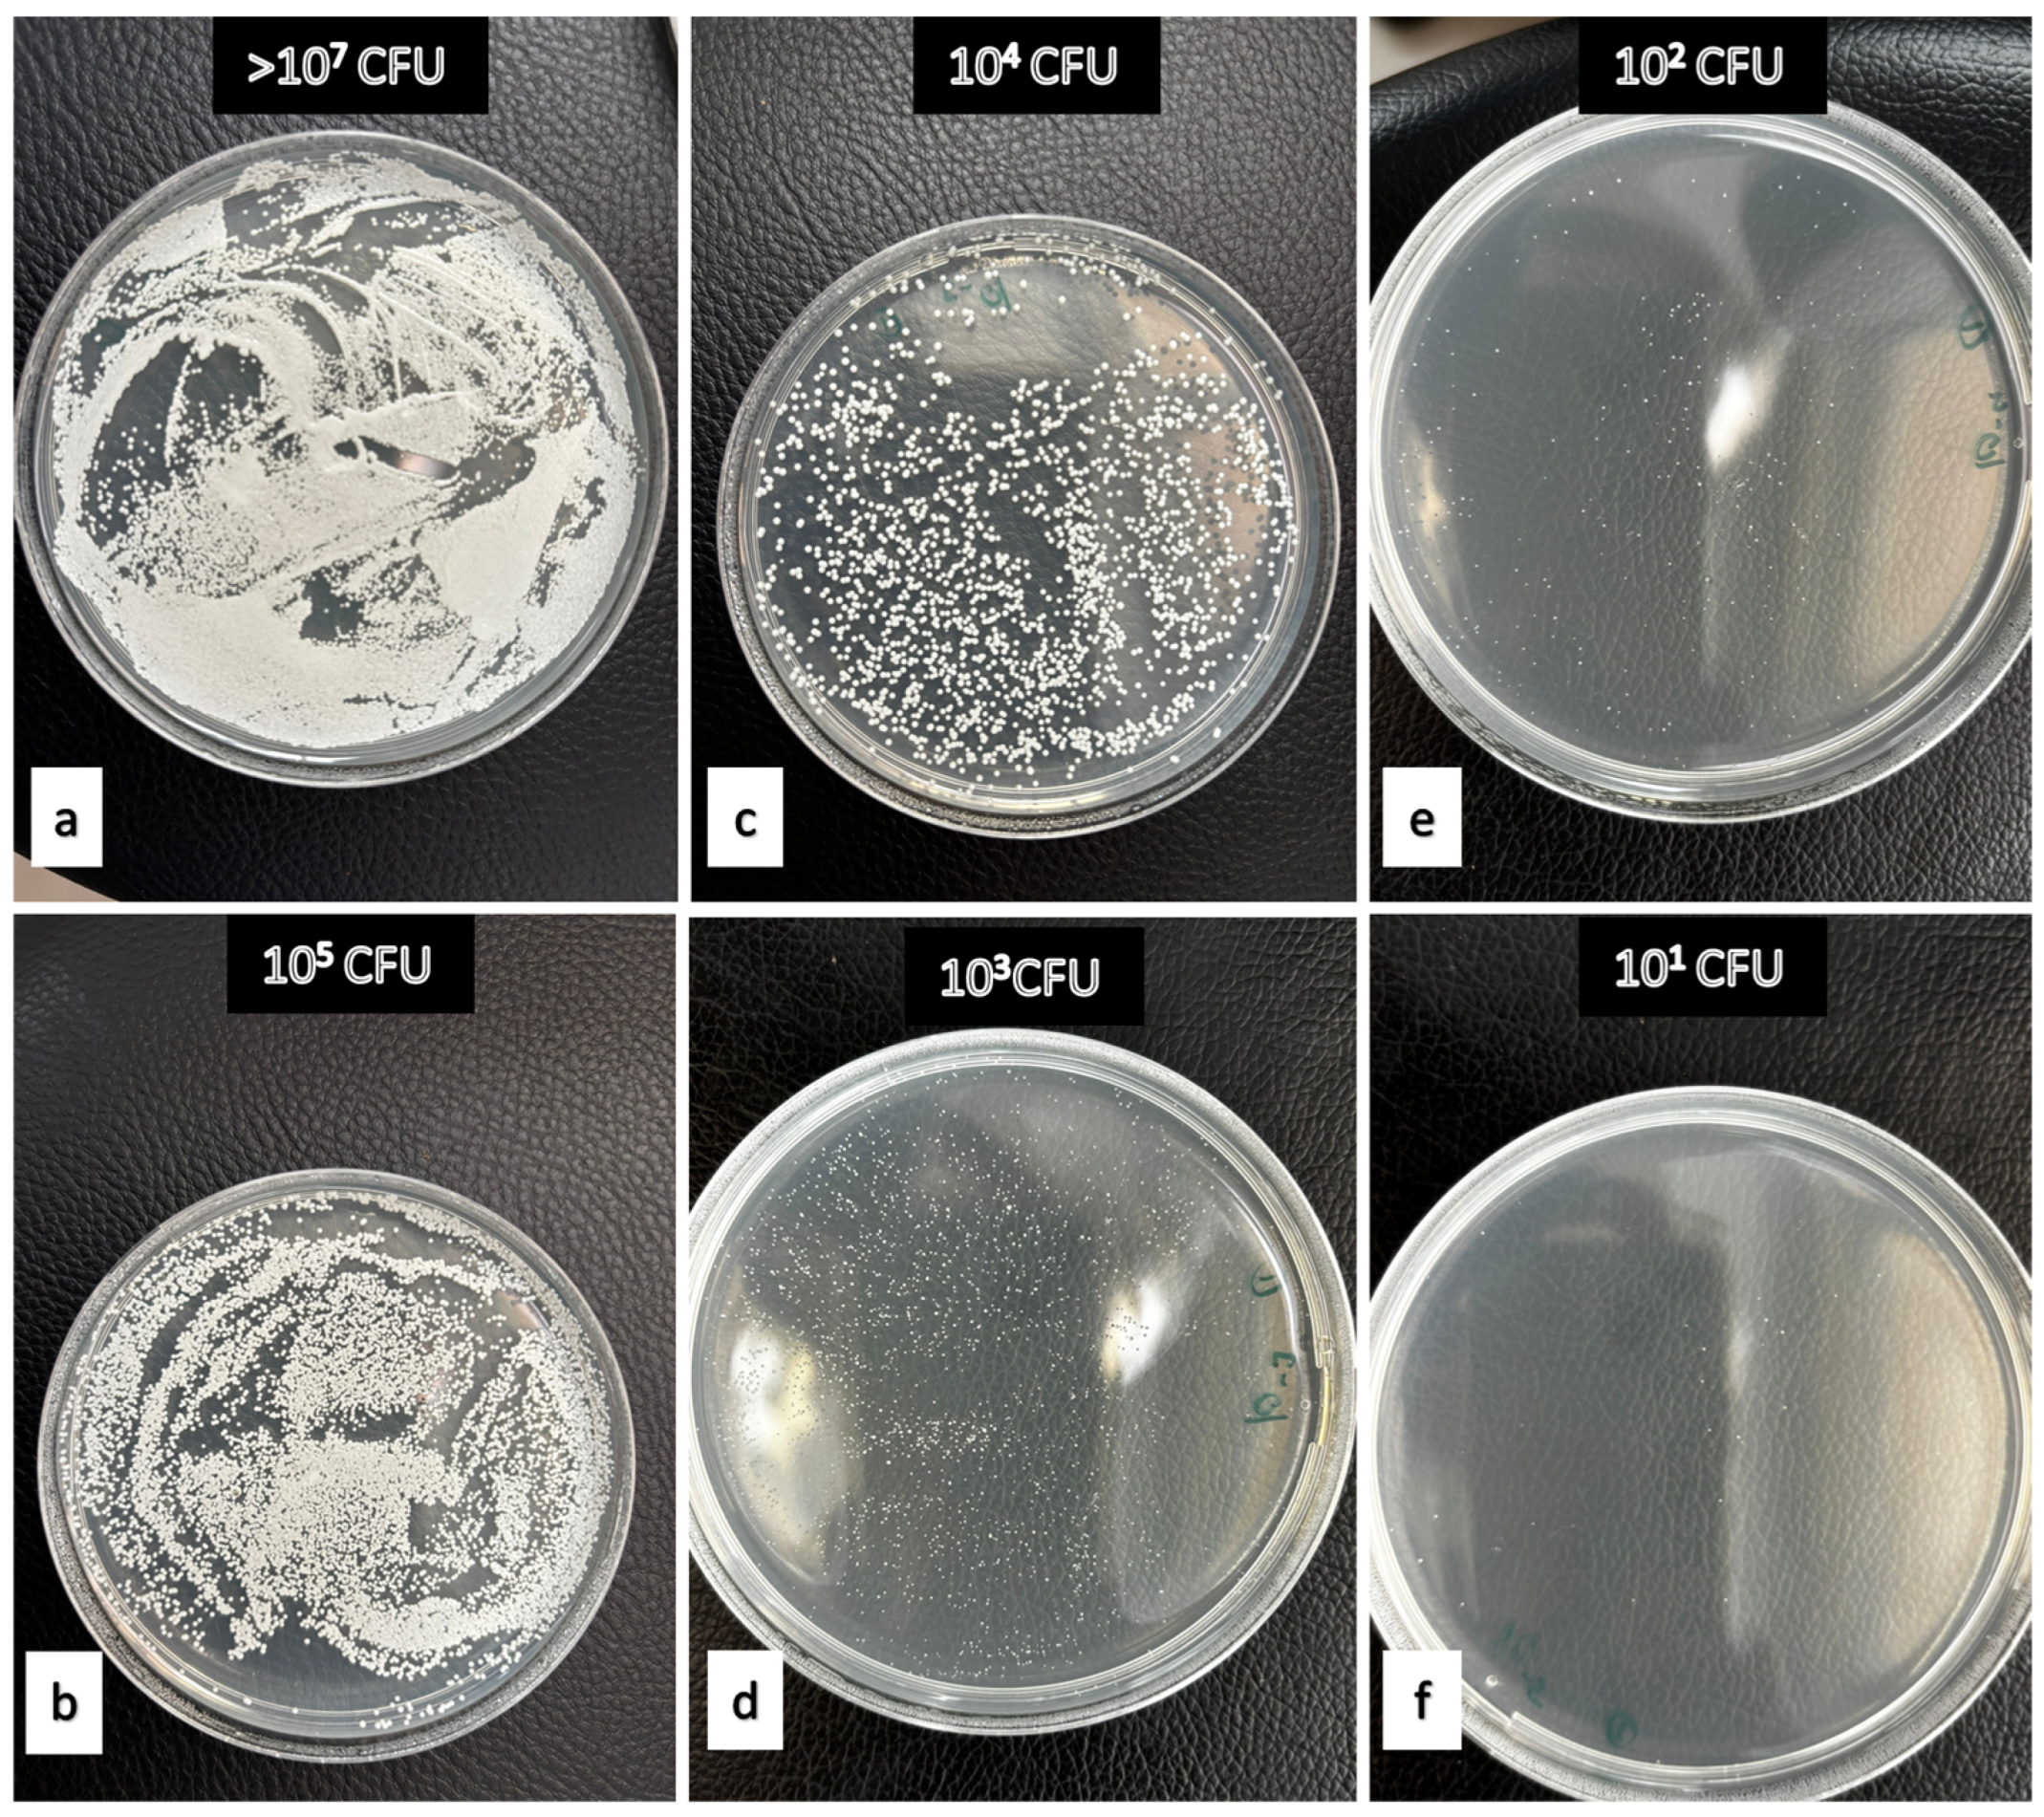
Polymers 17 02869 g002 Polymers 17 02869 g002

In Vitro Evaluation of Plant Antimicrobials Against Candida albicans Biofilm on Denture Base Materials: A Comparison with Chemical Denture Cleansers
Abstract
1. Introduction
2. Materials and Methods
2.1. Preparation of Denture Base Materials
2.2. Ensuring C. albicans Involvement
2.3. Treatment of Resins with Active Ingredients
2.4. Candida albicans Growth After Treatments
2.5. Statistical Analysis
3. Results
4. Discussion
5. Conclusions
Author Contributions
Funding
Institutional Review Board Statement
Data Availability Statement
Acknowledgments
Conflicts of Interest
Abbreviations
| PMMA | Polymethyl methacrylate |
| CHX | Clorhexidin |
| Ra | Surface roughness |
| SDB | Sabouraud dextrose broth |
| SDA | Sabouraud dextrose agar |
| DMSO | Dimethyl sulfoxide |
| OD | Optical density |
| CI | Confidence interval |
References
- Aslan, R.; Taskin, A.H.; Hasbek, M.; Celik, C. Evaluation of in vitro antimicrobial effect of different essential oils. Turk. Bull. Hyg. Exp. Biol. 2021, 78, 525–534. [Google Scholar] [CrossRef]
- Wyszyńska, M.; Nitsze-Wierzba, M.; Białożyt-Bujak, E.; Kasperski, J.; Skucha-Nowak, M. The problem of halitosis in prosthetic dentistry, and new approaches to its treatment: A literature review. J. Clin. Med. 2021, 10, 5560. [Google Scholar] [CrossRef]
- Brookes, Z.L.; Bescos, R.; Belfield, L.A.; Ali, K.; Robert, A. Current uses of chlorhexidine for management of oral disease: A narrative review. J. Dent. 2020, 103, 103497. [Google Scholar] [CrossRef]
- Bae, C.H.; Lim, Y.K.; Kook, J.K.; Son, M.K.; Heo, Y.R. Evaluation of antibacterial activity against Candida albicans according to the dosage of various denture cleansers. J. Adv. Prosthodont. 2021, 13, 100–106. [Google Scholar] [CrossRef]
- Bida, C.; Tudorici, T.; Bosinceanu, D.N.; Tunaru, O.I.; Budala, D.G. Advancements in understanding the development of Candida-associated denture stomatitis. Rom. J. Med. Dent. Educ. 2024, 13, 4. [Google Scholar]
- Lee, M.J.; Kim, M.J.; Mangal, U.; Seo, J.Y.; Kwon, J.S.; Choi, S.H. Zinc-modified phosphate-based glass micro-filler improves C. albicans resistance of auto-polymerized acrylic resin without altering mechanical performance. Sci. Rep. 2022, 12, 19456. [Google Scholar] [CrossRef]
- Hayran, Y.; Deniz, S.T.; Aydın, A. Antimicrobial activity of ozone against pathogenic oral microorganisms on different denture base resins. Ozone Sci. Eng. 2020, 42, 43–53. [Google Scholar] [CrossRef]
- King, E.; Jagger, R. Denture cleaning—Best practice. Dent. Update 2019, 46, 1024–1030. [Google Scholar]
- Srimaneepong, V.; Thanamee, T.; Wattanasirmkit, K.; Muangsawat, S.; Matangkasombut, O. Efficacy of low-molecular-weight chitosan against C. albicans biofilm on polymethyl methacrylate resin. Aust. Dent. J. 2021, 66, 262–269. [Google Scholar] [CrossRef] [PubMed]
- Ayaz, E.A.; Ustun, S. Effect of staining and denture cleaning on color stability of differently polymerized denture base acrylic resins. Niger. J. Clin. Pract. 2020, 23, 304–309. [Google Scholar] [CrossRef]
- Geckili, O. Maintenance. In Removable Partial Dentures: A Practitioners’ Manual; Springer International Publishing: Cham, Switzerland, 2024; pp. 373–395. [Google Scholar]
- Schmutzler, A.; Rauch, A.; Nitschke, I.; Lethaus, B.; Hahnel, S. Cleaning of removable dental prostheses—A systematic review. J. Evid. Based Dent. Pract. 2021, 21, 101644. [Google Scholar] [CrossRef]
- McReynolds, D.E.; Moorthy, A.; Moneley, J.O.C.; Jabra-Rizk, M.A.; Sultan, A.S. Denture stomatitis—An interdisciplinary clinical review. J. Prosthodont. 2023, 32, 560–570. [Google Scholar] [CrossRef] [PubMed]
- Yudaev, P.A.; Chistyakov, E.M. Progress in dental materials: Application of natural ingredients. Russ. Chem. Rev. 2024, 93, 251–280. [Google Scholar] [CrossRef]
- Sayar, F.; Karimi, M.R.; Boroujerdi, S. Efficacy of antimicrobial photodynamic therapy with chitosan nanoparticles for decontamination of dental implants contaminated with Aggregatibacter actinomycetemcomitans. Sci. Rep. 2025, 15, 34213. [Google Scholar] [CrossRef] [PubMed]
- Teixeira, A.B.V.; da Costa Valente, M.L.; Sessa, J.P.N.; Gubitoso, B.; Schiavon, M.A.; Dos Reis, A.C. Adhesion of biofilm, surface characteristics, and mechanical properties of antimicrobial denture base resin. J. Adv. Prosthodont. 2023, 15, 80. [Google Scholar] [CrossRef]
- Dalwai, S.; Rodrigues, S.J.; Baliga, S.; Shenoy, V.K.; Shetty, T.B.; Pai, U.Y.; Saldanha, S. Comparative evaluation of antifungal action of tea tree oil, chlorhexidine gluconate and fluconazole on heat polymerized acrylic denture base resin—An in vitro study. Gerodontology 2016, 33, 402–409. [Google Scholar] [CrossRef]
- Kumar, M.N.; Thippeswamy, H.M.; Swamy, K.R.; Gujjari, A.K. Efficacy of commercial and household denture cleansers against C. albicans adherent to acrylic denture base resin: An in vitro study. Indian J. Dent. Res. 2012, 23, 39–42. [Google Scholar] [CrossRef]
- Doddanna, S.J.; Patel, S.; Sundarrao, M.A.; Veerabhadrappa, R.S. Antimicrobial activity of plant extracts on C. albicans: An in vitro study. Indian J. Dent. Res. 2013, 24, 401–405. [Google Scholar] [CrossRef]
- Khan, S.A.; Mirani, Z.A.; Khalid, T.; Khan, E.M.W.A.; Choudhary, Z.; Kazmi, S.M.R. Effect of polishing methods on Candida albicans adhesion and contributing factors in heat-cured acrylic dentures: An in-vitro comparative study. BMC Oral Health 2025, 25, 197. [Google Scholar] [CrossRef]
- Sağsöz, N.P.; Güven, L.; Gür, B.; Sezer, C.V.; Cengiz, M.; Orhan, F.; Barış, Ö. Different essential oils can inhibit Candida albicans biofilm formation on acrylic resin by suppressing aspartic proteinase: In vitro and in silico approaches. Clin. Oral Investig. 2025, 29, 94. [Google Scholar] [CrossRef]
- Martorano-Fernandes, L.; Ricomini-Filho, A.P.; Cury, A.A.D.B. Does Streptococcus oralis supernatant influence the proliferation and virulence of Candida albicans? Arch. Oral Biol. 2023, 154, 105763. [Google Scholar] [CrossRef]
- Polat, N.; Orhan, F.; Barış, Ö. The effect of denture cleansing agent concentration and application time on C. albicans uptake on denture base material. Selcuk Dent. J. 2023, 10, 36–39. [Google Scholar] [CrossRef]
- Abuzar, M.A.; Bellur, S.; Duong, N.; Kim, B.B.; Lu, P.; Palfreyman, N.; Surendran, D.; Tran, V.T. Evaluating surface roughness of a polyamide denture base material in comparison with poly(methyl methacrylate). J. Oral Sci. 2010, 52, 577–581. [Google Scholar] [CrossRef]
- Freitas-Fernandes, F.S.; Cavalcanti, Y.W.; Ricomini-Filho, A.P.; Silva, W.J.; Cury, A.A.D.B.; Bertolini, M.M. Effect of daily use of an enzymatic denture cleanser on C. albicans biofilms formed on polyamide and poly(methyl methacrylate) resins: An in vitro study. J. Prosthet. Dent. 2014, 112, 1349–1355. [Google Scholar] [CrossRef]
- Vojdani, M.; Giti, R. Polyamide as a denture base material: A literature review. J. Dent. 2015, 16, 1–9. [Google Scholar]
- Bohlouli, S.; Esmaeilzadeh, M.; Negahdari, R.; Rezaei, Y.; Mehri, Z.; Aghazadeh, Z. Efficacy of Corega® solution, chlorhexidine (CHX) mouthwash, and Rojin bleaching solution in removing stains from dentures. J. Adv. Chem. Pharm. Mater. 2022, 5, 1–8. [Google Scholar]
- Coimbra, F.C.T.; Rocha, M.M.; Oliveira, V.C.; Macedo, A.P.; Pagnano, V.O.; Silva-Lovato, C.H.; Paranhos, H.F.O. Antimicrobial activity of effervescent denture tablets on multispecies biofilms. Gerodontology 2021, 38, 87–94. [Google Scholar] [CrossRef]
- Geduk, Ş.E.; Sağlam, G.; Cömert, F.; Geduk, G. Antimicrobial activity of cleanser tablets against S. mutans and C. albicans on different denture base materials. BMC Oral Health 2024, 24, 633. [Google Scholar] [CrossRef]
- Brookes, Z.; McGrath, C.; McCullough, M. Antimicrobial mouthwashes: An overview of mechanisms—What do we still need to know? Int. Dent. J. 2023, 73, 64–68. [Google Scholar] [CrossRef]
- Darmani, H.; Al-Saleh, D.R.H. Oral rinses: Some kill and some cripple Candida albicans. Med. Princ. Pract. 2024, 33, 338–346. [Google Scholar] [CrossRef]
- Gupta, P.; Pruthi, V.; Poluri, K.M. Mechanistic insights into Candida biofilm eradication potential of eucalyptol. J. Appl. Microbiol. 2021, 131, 105–123. [Google Scholar] [CrossRef]
- Akyıldız, G.; Duymus, Z.; Alpay Karaoğlu, Ş.; Bozdeveci, A. The effect of disinfection methods on C. albicans in three types of denture base materials. Mater. Plast. 2023, 60, 25–32. [Google Scholar] [CrossRef]
- Zhang, C.; Liu, B.; Hu, J.; Zhao, L.; Zhao, H. The effect of local application of tea tree oil adjunctive to daily oral maintenance and nonsurgical periodontal treatment: A systematic review and meta-analysis of randomised controlled studies. Oral Health Prev. Dent. 2024, 22, 1. [Google Scholar]
- Wiatrak, K.; Morawiec, T.; Rój, R.; Mertas, A.; Machorowska-Pieniążek, A.; Kownacki, P.; Tanasiewicz, M.; Skucha-Nowak, M.; Baron, S.; Piekarz, T.; et al. Oral health of patients treated with acrylic partial dentures using a toothpaste containing bee product. Evid Based Complement. Alternat. Med. 2017, 2017, 4034179. [Google Scholar] [CrossRef]
- Schmidt, E.; Bail, S.; Buchbauer, G.; Stoilova, I.; Atanasova, T.; Stoyanova, A.; Krastanov, A.; Schmidt, E. Chemical composition, olfactory evaluation and antioxidant effects of essential oil from Mentha × piperita. Nat. Prod. Commun. 2009, 4, 1934578X0900400819. [Google Scholar] [CrossRef]
- Hudz, N.; Kobylinska, L.; Pokajewicz, K.; Horčinová Sedláčková, V.; Fedin, R.; Voloshyn, M.; Myskiv, I.; Brindza, J.; Wieczorek, P.P.; Lipok, J. Mentha piperita: Essential oil and extracts, their biological activities, and perspectives on the development of new medicinal and cosmetic products. Molecules 2023, 28, 7444. [Google Scholar] [CrossRef]
- Yasin, M.; Younis, A.; Javed, T.; Akram, A.; Ahsan, M.; Shabbir, R.; Ali, M.M.; Tahir, A.; El-Ballat, E.M.; Sheteiwy, M.S.; et al. River tea tree oil: Composition, antimicrobial and antioxidant activities, and potential applications in agriculture. Plants 2021, 10, 2105. [Google Scholar] [CrossRef]
- Carson, C.F.; Hammer, K.A.; Riley, T.V. Melaleuca alternifolia (tea tree) oil: A review of antimicrobial and other medicinal properties. Clin. Microbiol. Rev. 2006, 19, 50–62. [Google Scholar] [CrossRef]
- Kosarsoy Agceli, G.; Hammamchi, H.; Cihangir, N. Novel levan/bentonite/essential oil films: Characterization and antimicrobial activity. J. Food Sci. Technol. 2022, 59, 249–256. [Google Scholar] [CrossRef]
- Pramila, D.M.; Xavier, R.; Marimuthu, K.; Kathiresan, S.; Khoo, M.L.; Senthilkumar, M.; Sathya, K.; Sreeramanan, S. Phytochemical analysis and antimicrobial potential of methanolic leaf extract of peppermint (Mentha piperita, Lamiaceae). J. Med. Plants Res. 2012, 6, 331–335. [Google Scholar] [CrossRef]
- Lomlim, L.; Manuschai, J.; Ratti, P.; Kara, J.; Sakunphueak, A.; Panichayupakaranant, P.; Naorungroj, S. Effect of alkynyloxy derivatives of lawsone as an antifungal spray for acrylic denture base: An in vitro study. Heliyon 2023, 9, e13919. [Google Scholar] [CrossRef]
- Sulieman, A.M.E.; Abdelrahman, S.E.; Abdel Rahim, A.M. Phytochemical analysis of local spearmint (Mentha spicata) leaves and detection of the antimicrobial activity of its oil. J. Microbiol. Res. 2011, 1, 1–4. [Google Scholar] [CrossRef]
- O’Donnell, L.E.; Alalwan, H.K.; Kean, R.; Calvert, G.; Nile, C.J.; Lappin, D.F.; Sherry, L. Candida albicans biofilm heterogeneity does not influence denture stomatitis but strongly influences denture cleansing capacity. J. Med. Microbiol. 2017, 66, 54–60. [Google Scholar] [PubMed]
- Khan, M.A.; Dhaded, S.; Joshi, S. Commercial and plant extract denture cleansers in prevention of C. albicans growth on soft denture reliner: In vitro study. J. Clin. Diagn. Res. 2016, 10, 42–45. [Google Scholar] [CrossRef]

| Commercial Name | Manufacturer | Composition | |
|---|---|---|---|
| Effervescent Tablet | Corega | Block Drug Company, Jersey City, NJ, USA | Potassium monopersulfate, Sodium bicarbonate, Sodium perborate monohydrate, Sodium phosphate |
| Protefix | Queisser Pharma, Flensburg, Germany | Sodium bicarbonate, Potassium caroate, Sodium perborate, Citric acid, Sodium lauryl sulfate, Aroma | |
| Liquid cleansers | Listerine | Johnson&Johnson, Italy | Eucalyptol, thymol, and menthol |
| Chlorhexidine gluconate | Zag Chemistry, İstanbul, Turkey | %20 Chem pure |
| Trade Name | Essential Oil Name /Latin Name | Manufacturer | Content |
|---|---|---|---|
| Tea tree oil | Melaleuca alternifolia | Botalife | Epigallocatechin gallate and epicatechin |
| Peppermint oil | Mentha piperita | Flora Anatolia | Monoterpenes derivatives |
| Apple cider vinegar | Apple vinegar | Kühne | Acetic acid |
| Effect | F-Statistic | p-Value (PR(>F)) | Partial η2 | Interpretation |
|---|---|---|---|---|
| Active Ingredients | 153.308 | 3.28 × 10−39 | 0.6543 | Very Large Effect |
| Active Ingredients × Denture Base | 12.788 | 3.32 × 10−10 | 0.2685 | Large Effect |
| Time | 0.000 | 0.9999 | 0.0000 | Negligible Effect |
| Denture Base | 0.000 | 0.9997 | 0.0000 | Negligible Effect |
| Other Interactions | … | ≈1.000 | ≈0.0000 | Negligible Effect |
| Treatment Group | Material | Mean CFU | 95% Lower CI | 95% Upper CI |
|---|---|---|---|---|
| Listerine 2% | PMMA (Acrylic) | 1.45 | 1.42 | 1.49 |
| Listerine 2% | PA (Polyamide) | 1.41 | 1.34 | 1.48 |
| Listerine 20% | PMMA (Acrylic) | 0.67 | 0.63 | 0.70 |
| Listerine 20% | PA (Polyamide) | 0.79 | 0.68 | 0.89 |
| Peppermint Oil | PMMA (Acrylic) | 1.25 | 0.92 | 1.58 |
| Peppermint Oil | PA (Polyamide) | 1.33 | 1.03 | 1.64 |
| Control (Group 10) | PMMA (Acrylic) | 110.25 | 103.31 | 117.19 |
| Control (Group 10) | PA (Polyamide) | 175.90 | 159.77 | 192.03 |
| Active Ingredient/ Concentrations | Application Time | ||||||||
|---|---|---|---|---|---|---|---|---|---|
| Acrylic (PMMA) Mean ± Standard Deviation (SD) | Polyamide (Deflex) Mean ± Standard Deviation (SD) | ||||||||
| 5 m | 15 m | 30 m | 480 m | 5 m | 15 m | 30 m | 480 m | ||
| Listerine | 2% | 1.504 ±0.034 | 1.489 ±0.02 | 1.47 ±0.039 | 1.348 ±0.071 | 1.506 ±0.083 | 1.474 ±0.154 | 1.449 ±0.134 | 1.211 ±0.044 |
| 20% | 0.72 ±0.048 | 0.652 ±0.079 | 0.655 ±0.077 | 0.648 ±0.079 | 0.996 ±0.029 | 0.919 ±0.089 | 0.739 ±0.178 | 0.494 ±0.025 | |
| 50% | 0 | 0 | 0 | 0 | 0.201 ±0.014 | 0.168 ±0.045 | 0 | 0 | |
| Corega | 150 mL/1 tablet | 0 | 0 | 0 | 0 | 0 | 0 | 0 | 0 |
| Protefix | 150 mL/1 tablet | 0 | 0 | 0 | 0 | 0.1 ±0.007 | 0.001 ±0.00007 | 0 | 0 |
| Apple vinegar | 15% | 0 | 0 | 0 | 0 | 0.486 ±0.04 | 0.057 ±0.018 | 0.001 ±0.00011 | 0 |
| Tea tree oil | 2% | 0.05 ±0.0033 | 0.038 ±0.013 | 0 | 0 | 0.051 ±0.008 | 0.041 ±0.008 | 0.01 ±0.0009 | 0 |
| Peppermint oil | 2% | 1.565 ±0.745 | 1.364 ±0.646 | 0.914 ±0.692 | 1.148 ±0.796 | 1.902 ±0.474 | 1.064 ±0.591 | 1.206 ±0.503 | 1.156 ±0.788 |
| PC (CHX) | 2% | 0 | 0 | 0 | 0 | 0 | 0 | 0 | 0 |
| NC | - | 112.6 ±12.602 | 110.8 ±11.52 | 108 ±16.508 | 109.6 ±21.617 | 181 ±35.43 | 179.2 ±35.885 | 171.8 ±36.765 | 171.6 ±40.722 |
| Active Ingredient | Materials | F | Sig. |
|---|---|---|---|
| Listerine 2% | Acrylic | 1.760 | 0.245 |
| Listerine 2% | Polyamide | 1.292 | 0.342 |
| Listerine 20% | Acrylic | 0.441 | 0.725 |
| Listerine 20% | Polyamide | 2.492 | 0.141 |
| Listerine 50% | Polyamide | 35.590 | 0.000 |
| Peppermint oil | Acrylic | 3.744 | 0.047 |
| Peppermint oil | Polyamide | 1.762 | 0.245 |
| Active Ingredient | Application Time | Mean Difference | Sig. (2-Tailed) |
|---|---|---|---|
| Listerine 2% | 5 m | −0.0022 | 0.957 |
| Listerine 2% | 15 m | 0.0144 | 0.84 |
| Listerine 2% | 30 m | 0.021 | 0.745 |
| Listerine 2% | 480 m | 0.137 | 0.006 |
| Listerine 20% | 5 m | −0.2758 | 0.000 |
| Listerine 20% | 15 m | −0.267 | 0.001 |
| Listerine 20% | 30 m | −0.084 | 0.362 |
| Listerine 20% | 480 m | 0.1536 | 0.003 |
| Tea tree oil | 5 m | −0.00172 | 0.68 |
| Tea tree oil | 15 m | −0.00266 | 0.704 |
| Peppermint oil | 5 m | −0.3372 | 0.418 |
| Peppermint oil | 15 m | 0.3 | 0.465 |
| Peppermint oil | 30 m | −0.2922 | 0.467 |
| Peppermint oil | 480 m | −0.0082 | 0.987 |
| NC | 5 m | −68.4 | 0.004 |
| NC | 15 m | −68.4 | 0.011 |
| NC | 30 m | −63.8 | 0.014 |
| NC | 480 m | −62 | 0.023 |
Disclaimer/Publisher’s Note: The statements, opinions and data contained in all publications are solely those of the individual author(s) and contributor(s) and not of MDPI and/or the editor(s). MDPI and/or the editor(s) disclaim responsibility for any injury to people or property resulting from any ideas, methods, instructions or products referred to in the content. |
© 2025 by the authors. Licensee MDPI, Basel, Switzerland. This article is an open access article distributed under the terms and conditions of the Creative Commons Attribution (CC BY) license (https://creativecommons.org/licenses/by/4.0/).
Share and Cite
Polat Sagsoz, N.; Orhan, F.; Baris, O.; Sagsoz, O. In Vitro Evaluation of Plant Antimicrobials Against Candida albicans Biofilm on Denture Base Materials: A Comparison with Chemical Denture Cleansers. Polymers 2025, 17, 2869. https://doi.org/10.3390/polym17212869
Polat Sagsoz N, Orhan F, Baris O, Sagsoz O. In Vitro Evaluation of Plant Antimicrobials Against Candida albicans Biofilm on Denture Base Materials: A Comparison with Chemical Denture Cleansers. Polymers. 2025; 17(21):2869. https://doi.org/10.3390/polym17212869
Chicago/Turabian StylePolat Sagsoz, Nurdan, Figen Orhan, Ozlem Baris, and Omer Sagsoz. 2025. "In Vitro Evaluation of Plant Antimicrobials Against Candida albicans Biofilm on Denture Base Materials: A Comparison with Chemical Denture Cleansers" Polymers 17, no. 21: 2869. https://doi.org/10.3390/polym17212869
APA StylePolat Sagsoz, N., Orhan, F., Baris, O., & Sagsoz, O. (2025). In Vitro Evaluation of Plant Antimicrobials Against Candida albicans Biofilm on Denture Base Materials: A Comparison with Chemical Denture Cleansers. Polymers, 17(21), 2869. https://doi.org/10.3390/polym17212869

